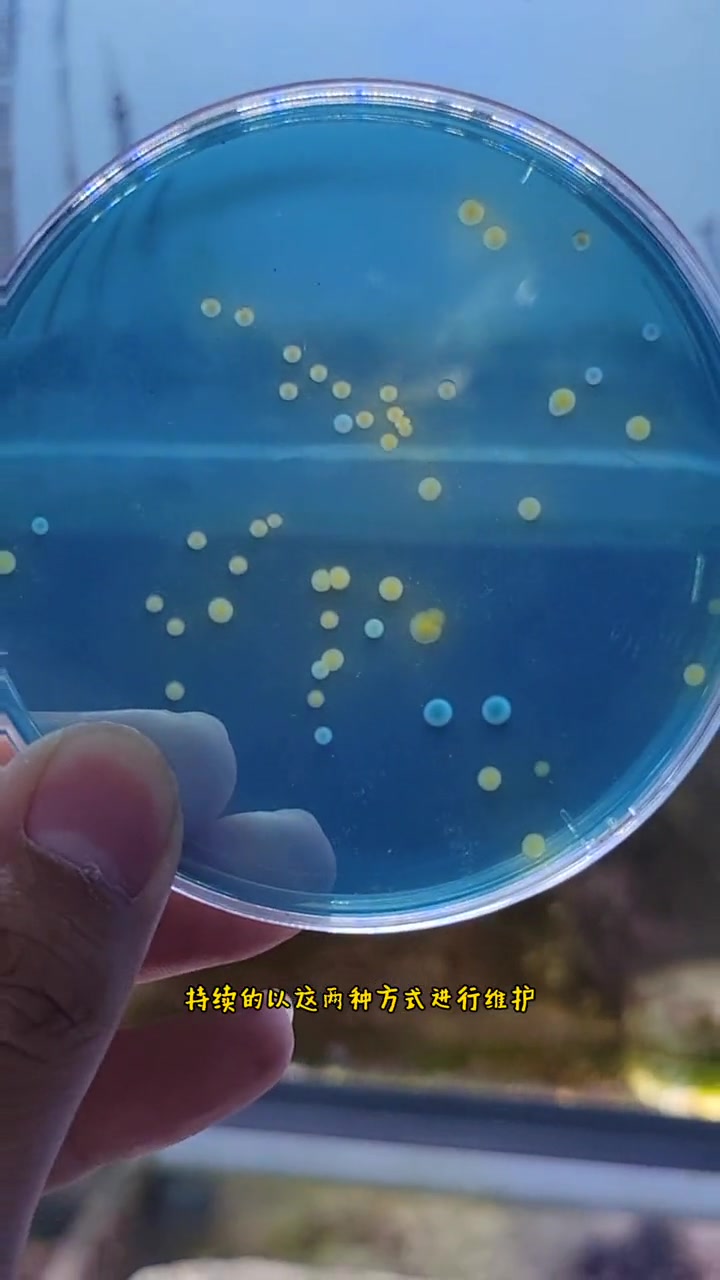
海缸小知识，小丑鱼繁殖(十)弧菌检测2 小丑鱼 小丑鱼尼莫 小丑鱼繁殖 小丑鱼繁殖专用鱼粮

观赏鱼鱼缸批发相关视频
观赏鱼鱼缸批发视频列表
-
03:46
过来广州百艺城观赏鱼批发市场,了解泰国斗鱼行情,遇到鱼缸爆裂 用户:广州胜哥 -
 00:27
超过三十条的鱼挤在同一条鱼缸,网友:这氧气是不是不够用 用户:岳阳晚报
00:27
超过三十条的鱼挤在同一条鱼缸,网友:这氧气是不是不够用 用户:岳阳晚报 -
 02:12
02:12
-
 01:10
鱼又跳缸了!今天必须给鱼缸装防跳网,养鱼人太难了 用户:大冲养鱼日记
01:10
鱼又跳缸了!今天必须给鱼缸装防跳网,养鱼人太难了 用户:大冲养鱼日记 -
 00:59
100块买1斤观赏鱼,另类宠物弹涂鱼,放进鱼缸,你会发现它很好玩 用户:一二水族
00:59
100块买1斤观赏鱼,另类宠物弹涂鱼,放进鱼缸,你会发现它很好玩 用户:一二水族 -
 01:02
如果你很顺利,鱼缸里就不要养这种鱼 用户:心灵捕手屋
01:02
如果你很顺利,鱼缸里就不要养这种鱼 用户:心灵捕手屋 -
00:16
方寸轻奢极简水族箱 #龙鱼缸 #水族 #鱼缸 #养鱼 #水族箱 #观赏鱼 #龙 用户:博特水族工厂 -
04:17
为什么饲养了四缸小型观赏鱼,最担心的反而是红绿灯呢? 用户:养鱼老道 -
 00:14
男子在家中建10米长鱼缸养巨骨舌鱼:一共养了9条,单条鱼价值 用户:深度热点解剖师
00:14
男子在家中建10米长鱼缸养巨骨舌鱼:一共养了9条,单条鱼价值 用户:深度热点解剖师 -
00:41
海缸小知识,小丑鱼繁殖(十)弧菌检测2 小丑鱼 小丑鱼尼莫 小丑鱼繁殖 小丑鱼繁殖专用鱼粮 用户:我们的海Oursea
00:41
海缸小知识,小丑鱼繁殖(十)弧菌检测2 小丑鱼 小丑鱼尼莫 小丑鱼繁殖 小丑鱼繁殖专用鱼粮 用户:我们的海Oursea -
01:41
国产三大美丽观赏鱼,河里就能捞到,放进鱼缸就知道多漂亮了 用户:一二水族 -
00:17
第四届中国水产种业大会观赏鱼展区观赏鱼缸 用户:可为渔业 -
00:19
-
 00:54
海缸小知识,小丑鱼繁殖(十六)种鱼缸的日常维护、打理!水族 小丑鱼繁殖 海水鱼珊瑚 养鱼日 用户:我们的海Oursea
00:54
海缸小知识,小丑鱼繁殖(十六)种鱼缸的日常维护、打理!水族 小丑鱼繁殖 海水鱼珊瑚 养鱼日 用户:我们的海Oursea -
01:29
你们竟然吃观赏鱼?我在鱼缸精心养鱼,你们却研究怎么吃 用户:一二水族 -
 00:15
让鱼儿游的更高,负压鱼缸 用户:阳洋爱养鱼
00:15
让鱼儿游的更高,负压鱼缸 用户:阳洋爱养鱼 -
 00:10
自带国风的观赏鱼,蝴蝶鲤!观赏鱼 鱼缸 用户:呜呼小飞鱼
00:10
自带国风的观赏鱼,蝴蝶鲤!观赏鱼 鱼缸 用户:呜呼小飞鱼 -
 01:46
第8集|海缸小知识,(5)用最便宜的设备饲养海水生物(美观、简洁、大气) 小丑鱼繁殖 海水 用户:我们的海Oursea
01:46
第8集|海缸小知识,(5)用最便宜的设备饲养海水生物(美观、简洁、大气) 小丑鱼繁殖 海水 用户:我们的海Oursea -
 05:38
观赏鱼批发市场这边卖的超白鱼缸,有没有比你们那边便宜?不便宜哦 用户:广州胜哥
05:38
观赏鱼批发市场这边卖的超白鱼缸,有没有比你们那边便宜?不便宜哦 用户:广州胜哥 -
 00:20
把你们的原生鱼缸发出来看一看。四川锦鲤鱼批发,锦鲤鱼苗批发。锦鲤鱼 四川锦鲤鱼苗 观赏鱼 用户:吉瑞达鱼苗养鱼场
00:20
把你们的原生鱼缸发出来看一看。四川锦鲤鱼批发,锦鲤鱼苗批发。锦鲤鱼 四川锦鲤鱼苗 观赏鱼 用户:吉瑞达鱼苗养鱼场 -
03:42
广州芳村观赏鱼便宜,鱼缸价格怎么样?热弯鱼缸容易爆裂不建议买 用户:广州胜哥 -
 03:02
这里观赏鱼市场,卖七彩神仙鱼才几百块钱,水族店零售价至少1300 用户:广州胜哥
03:02
这里观赏鱼市场,卖七彩神仙鱼才几百块钱,水族店零售价至少1300 用户:广州胜哥 -
 01:26
第2集|海缸小知识,(2)用最简单的设备养好小丑鱼。一套价值不到一百元的小丑鱼套缸!小丑鱼 用户:我们的海Oursea
01:26
第2集|海缸小知识,(2)用最简单的设备养好小丑鱼。一套价值不到一百元的小丑鱼套缸!小丑鱼 用户:我们的海Oursea